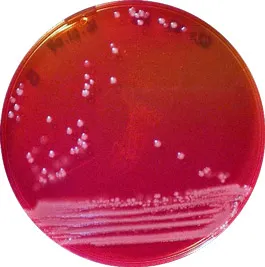

Selenite Broth Base
02-598
DIN / ISO
Liquid medium used for the enrichment of Salmonella and Shigella from clinical specimens and other products according to ISO 6785, 6340 Standards. This medium need to add Sodium Biselenite (Art. No.:SO0160).
The prepared medium (Art. No. 064-TA0138) contains sodium biselenite.
Synonyms: Selenite F Broth
DIN / ISO
Liquid medium used for the enrichment of Salmonella and Shigella from clinical specimens and other products according to ISO 6785, 6340 Standards. This medium need to add Sodium Biselenite (Art. No.:SO0160).
The prepared medium (Art. No. 064-TA0138) contains sodium biselenite.
Synonyms: Selenite F Broth

02-598
DIN / ISO
Liquid medium used for the enrichment of Salmonella and Shigella from clinical specimens and other products according to ISO 6785, 6340 Standards. This medium need to add Sodium Biselenite (Art. No.:SO0160).
The prepared medium (Art. No. 064-TA0138) contains sodium biselenite.
Synonyms: Selenite F Broth

Rest of the World
Rest of the World




